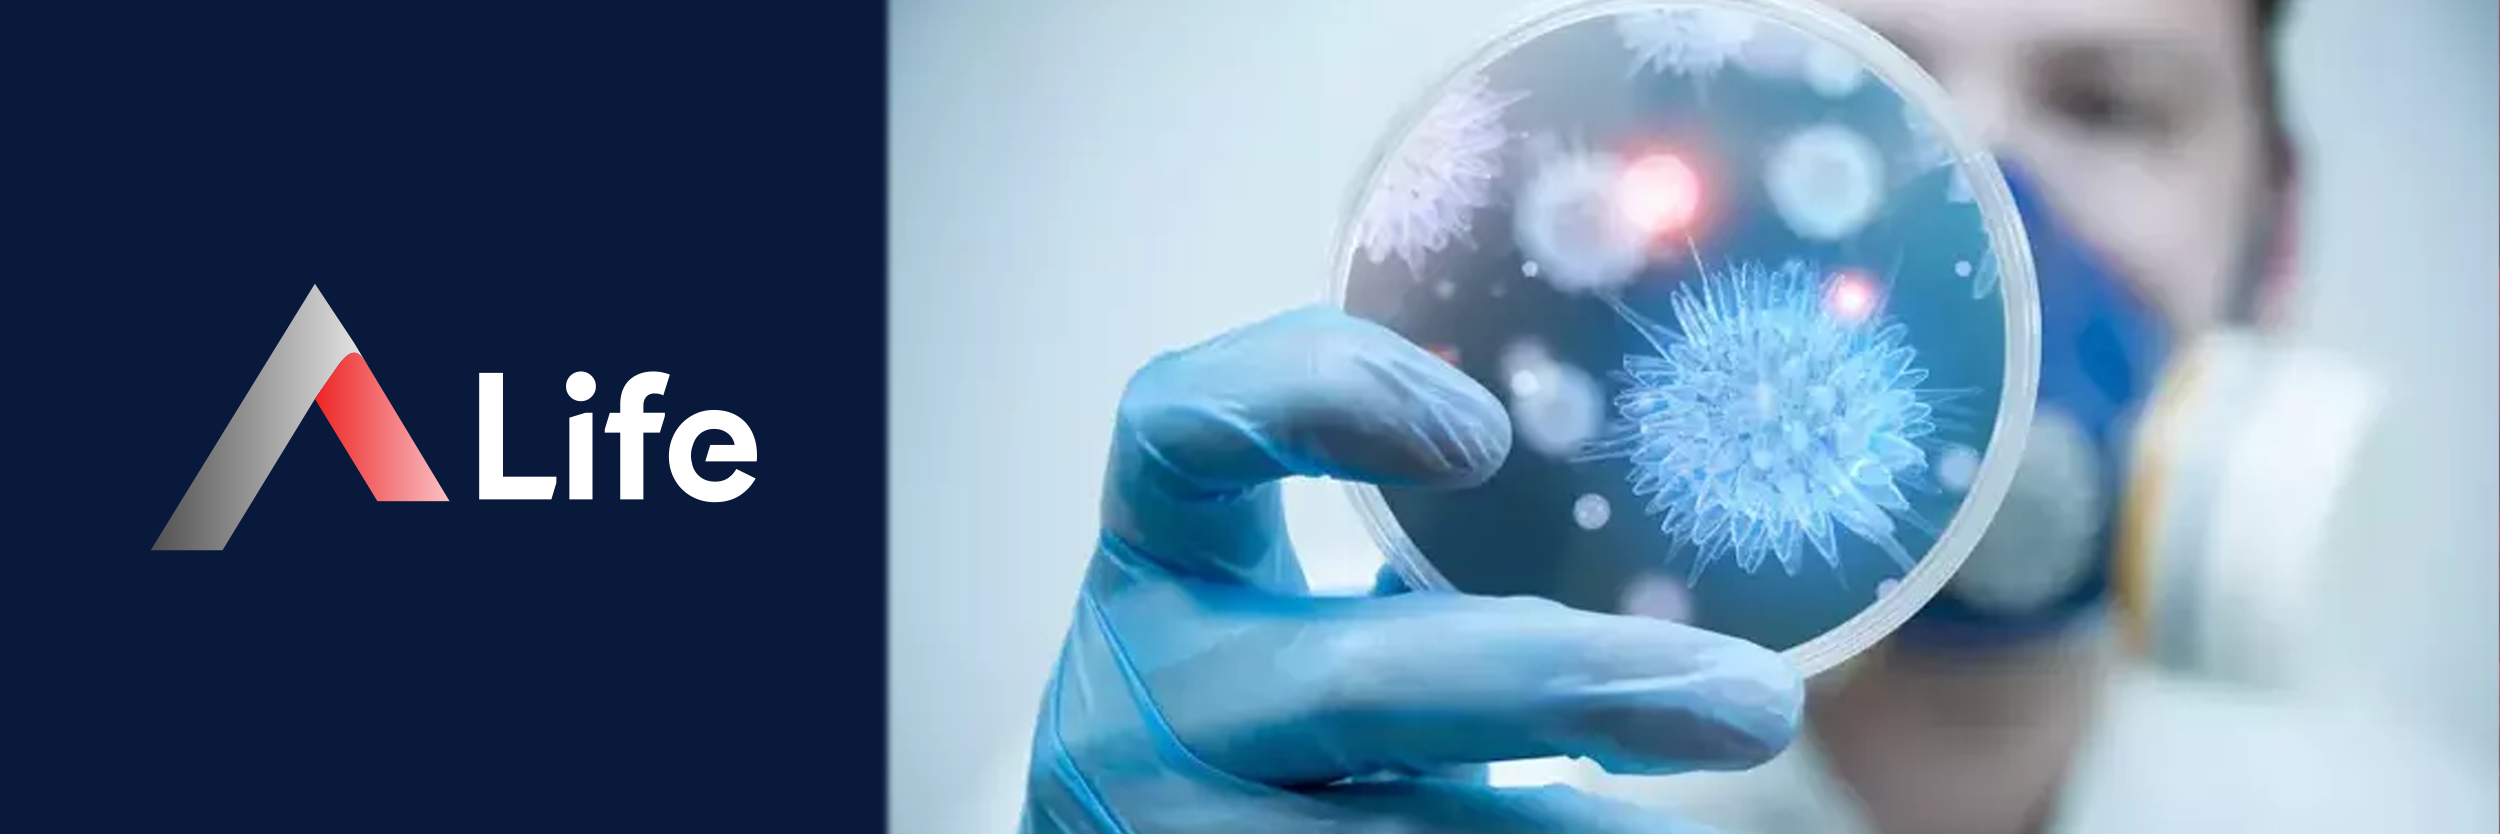
bula____c___hastal__klar_26d47d62.webp

Bulaşıcı hastalık, bir mikroorganizmanın vücuda girerek çoğalması ve çeşitli sistemleri etkileyerek hastalığa neden olmasıdır. Bu mikroorganizmalar; bakteriler, virüsler, mantarlar ve parazitler olabilir. Bulaş yolları ise oldukça çeşitli olup şunları içerir:
Solunum yolu (damlacık yoluyla)
Cilt teması
Kan ve vücut sıvıları
Cinsel temas
Kontamine su ve yiyecek tüketimi
Hayvan ısırıkları
Bulaşıcı hastalıklara neden olan mikroorganizmalar genellikle bağışıklık sistemi zayıf olan bireylerde daha kolay enfeksiyona yol açar. Başlıca nedenler şunlardır:
Hijyen eksikliği
Aşılama eksikliği
Sağlıksız beslenme
Bağışıklık sistemi zayıflığı
Yoğun nüfuslu yaşam alanları
Küresel seyahatler
Hayvanlarla temas
Grip virüsü hava yoluyla bulaşan, ateş, kas ağrısı, halsizlik gibi semptomlarla seyreden bir enfeksiyondur.
SARS-CoV-2 virüsünün neden olduğu bu hastalık ciddi solunum problemleri yaratabilir ve damlacık yoluyla bulaşır.
Mycobacterium tuberculosis bakterisinin neden olduğu bulaşıcı bir akciğer hastalığıdır.
Kan yoluyla bulaşan bu virüsler karaciğeri etkileyerek ciddi sağlık sorunlarına neden olabilir.
Bağışıklık sistemini çökerten HIV virüsü, cinsel temas ve kan yoluyla bulaşır.
Çocuklarda sık görülen, son derece bulaşıcı ve ateşli döküntüyle seyreden viral bir hastalıktır.
Varicella-zoster virüsünün neden olduğu, çocukluk çağında sık görülen, kaşıntılı döküntü ile seyreden bir hastalıktır.
Kuduz virüsü, enfekte hayvan ısırığıyla bulaşır ve sinir sistemini hedef alır.
Kontamine su ve gıdalarla bulaşan bakteriyel veya viral kaynaklı bir sindirim sistemi hastalığıdır.
Bakteri ya da virüslerin beyin zarını etkilemesiyle ortaya çıkan ciddi bir enfeksiyondur.
Her bulaşıcı hastalık farklı semptomlar gösterebilir. Ancak bazı yaygın belirtiler şunlardır:
Kas ağrısı
Lenf bezlerinde şişlik
Bulaş yolları, hastalığın türüne göre değişiklik gösterir:
Damlacık yoluyla (hapşırma, öksürme)
Cinsel temas
Kan ve vücut sıvıları
Kirli eller veya yüzeyler
Kontamine su ve yiyecekler
Vektörler (örneğin sivrisinekler, keneler)
Çocukluk döneminden itibaren yapılması gereken zorunlu aşılar, birçok bulaşıcı hastalığa karşı koruyuculuk sağlar.
Ellerin sabun ve suyla düzenli olarak yıkanması, mikropların yayılmasını önler.
Özellikle solunum yoluyla bulaşan hastalıklarda maske takmak, damlacıkların yayılmasını engeller.
Kondom kullanımı, HIV ve diğer cinsel yolla bulaşan hastalıkların riskini azaltır.
İyi pişmiş gıdaların tercih edilmesi ve temiz içme suyunun kullanılması önemlidir.
Dengeli beslenme, düzenli uyku ve fiziksel aktivite, bağışıklık sistemini güçlendirerek bulaşıcı hastalıklara karşı direnci artırır.
Erken tanı, hastalığın yayılmasını engellemek ve uygun tedaviye başlamak açısından kritiktir. Tanı yöntemleri şunlardır:
Boğaz kültürü
Gaita ve idrar tahlili
PCR testleri (özellikle viral enfeksiyonlarda)
Tedavi yöntemi hastalığın nedenine göre değişir:
Antibiyotikler: Bakteriyel enfeksiyonlarda kullanılır.
Antiviral ilaçlar: Virüs kaynaklı hastalıklarda etkilidir.
Ateş düşürücüler, ağrı kesiciler: Semptomları hafifletir.
Destekleyici bakım: Sıvı desteği, yatak istirahati, oksijen tedavisi gibi destekler sağlanabilir.
Bazı bireylerde bulaşıcı hastalıklar daha ağır seyredebilir:
Yaşlılar
Kronik hastalığı olanlar (kalp, şeker, KOAH)
Bağışıklığı baskılanmış kişiler (HIV, kanser tedavisi alanlar)
Hamile kadınlar
Çocuklar ve bebekler

Bulaşıcı hastalıklar, türüne ve tedavi sürecine göre farklılık göstermekle birlikte bazı durumlarda ölümcül sonuçlara yol açabilir. Özellikle tedavi edilmemiş ya da geç teşhis edilmiş hastalıklar, bağışıklık sistemi zayıf bireylerde ciddi komplikasyonlara neden olabilir. Tüberküloz, HIV/AIDS, hepatit B ve C, COVID-19, menenjit gibi hastalıklar doğru tedavi edilmezse kalıcı hasarlar bırakabilir ya da yaşamı tehdit edebilir. Ancak erken teşhis, düzenli doktor kontrolü ve doğru tedavi süreciyle bu hastalıkların büyük bölümü başarıyla yönetilebilir.
Bulaşıcı hastalıklar, bakteriler, virüsler, mantarlar ve parazitler yoluyla insandan insana geçebilen hastalıklardır. En yaygın bulaşıcı hastalıklar şunlardır:
Norovirüs (gıda zehirlenmeleriyle ilişkili) Bu hastalıkların bir kısmı solunum yoluyla, bir kısmı cilt teması, kan teması, dışkı veya cinsel temas gibi yollarla bulaşır.
Bulaşıcı hastalıklardan korunma için alınabilecek en etkili önlemler şunlardır:
Aşı takvimine uygun şekilde aşı olmak
Ellerin sık sık sabunla yıkanması
Maske kullanımı (özellikle solunum yoluyla bulaşan hastalıklarda)
Kalabalık ve kapalı ortamlardan uzak durmak
Bağışıklık sistemini güçlendirmek için sağlıklı beslenmek, uyku düzenine dikkat etmek
Kişisel hijyene dikkat etmek, ortak eşya kullanımından kaçınmak
Cinsel yolla bulaşan hastalıklardan korunmak için güvenli cinsel ilişki tercih etmek ve tek eşlilik
Hasta kişilerle yakın temastan kaçınmak ve hasta bireylerin izole edilmesi
Bu önlemlerle birçok bulaşıcı hastalığın yayılması önlenebilir ya da etkisi azaltılabilir.
Evet, birçok bulaşıcı hastalık cinsel yolla bulaşabilir. Bu hastalıklara genel olarak cinsel yolla bulaşan hastalıklar (CYBH) adı verilir. En yaygın olanlar:
HIV/AIDS
Hepatit B ve C
Frengi (sifiliz)
Bel soğukluğu (gonore)
HPV (Human Papilloma Virüsü)
Bu tür hastalıklar çoğu zaman belirti vermeden ilerleyebilir ve uzun vadede ciddi sağlık sorunlarına yol açabilir. Prezervatif kullanımı, düzenli sağlık kontrolleri ve tek eşlilik bu hastalıklardan korunmada önemli rol oynar. Cinsel yolla bulaşan bir hastalıktan şüpheleniyorsanız, vakit kaybetmeden uzman bir doktora başvurmanız önemlidir.
Bir hastalığın bulaşıcı olup olmadığını anlamanın en güvenilir yolu, uzman bir enfeksiyon hastalıkları doktoruna başvurarak gerekli laboratuvar testlerini yaptırmaktır. Özellikle yüksek ateş, ishal, öksürük, boğaz ağrısı, cilt döküntüsü, halsizlik, lenf bezi şişliği gibi belirtiler varsa, bu durumlar enfeksiyon hastalığına işaret edebilir.
Bununla birlikte:
Kan tahlili
Boğaz kültürü
İdrar ve dışkı analizi
PCR testleri gibi tetkiklerle hastalığın nedeni saptanabilir. Her ateşli hastalık bulaşıcı olmayabileceği gibi, bazı hastalıklar belirti vermeden de yayılabilir. Bu nedenle şüphe durumlarında tıbbi destek alınması büyük önem taşır.
Hayır, bulaşıcı hastalıkların seyri kişiden kişiye farklılık gösterebilir. Bu farklılık; bireyin yaşı, genetik yapısı, bağışıklık sistemi, beslenme alışkanlıkları, mevcut kronik hastalıkları ve hastalık etkenine maruz kalma süresi gibi faktörlere bağlıdır. Örneğin; COVID-19 genç ve sağlıklı bireylerde hafif seyrederken, yaşlı ya da kronik hastalığı olan kişilerde hayati risk oluşturabilir.
Evet, bazı bulaşıcı hastalıklar birden fazla kez geçirilebilir. Örneğin; grip virüsü, her yıl mutasyona uğradığı için kişiler birden fazla kez enfekte olabilir. Aynı şekilde, soğuk algınlığı, COVID-19, boğaz enfeksiyonları ve idrar yolu enfeksiyonları da tekrarlayabilir. Bu nedenle bağışıklık sistemini güçlü tutmak, hijyene dikkat etmek ve aşılama takvimini takip etmek tekrar riskini azaltır.
Hayır. Antibiyotikler yalnızca bakteriyel enfeksiyonlara karşı etkilidir. Grip, COVID-19, kızamık gibi viral hastalıklarda antibiyotikler etkili değildir. Bu nedenle her hastalıkta antibiyotik kullanımı yanlış ve zararlı olabilir. Yanlış antibiyotik kullanımı, antibiyotik direnci gelişmesine neden olur ve bu da gelecekte tedavisi zor enfeksiyonlara zemin hazırlar. Antibiyotik kullanımı mutlaka doktor önerisiyle ve reçeteyle yapılmalıdır.
A Life Sağlık Grubu olarak, bulaşıcı hastalıklarla mücadelede erken teşhis, etkili tedavi ve koruyucu sağlık hizmetleri sunuyoruz. Modern laboratuvarlarımızda tüm enfeksiyon testlerini gerçekleştirebilir, uzman doktorlarımızla birebir görüşerek sağlığınızı güvence altına alabilirsiniz. Sağlıkla ilgili sorularınız için web sitemiz ve mobil uygulamamız üzerinden randevu alabilir, canlı destek ile hemen iletişime geçebilirsiniz.

Araştırdığınız Hastalık Hakkında Uzman Hekimlerimiz Size Dönüş Sağlasın.
7/24 tüm soru ve sorunlarınız için buradayız.